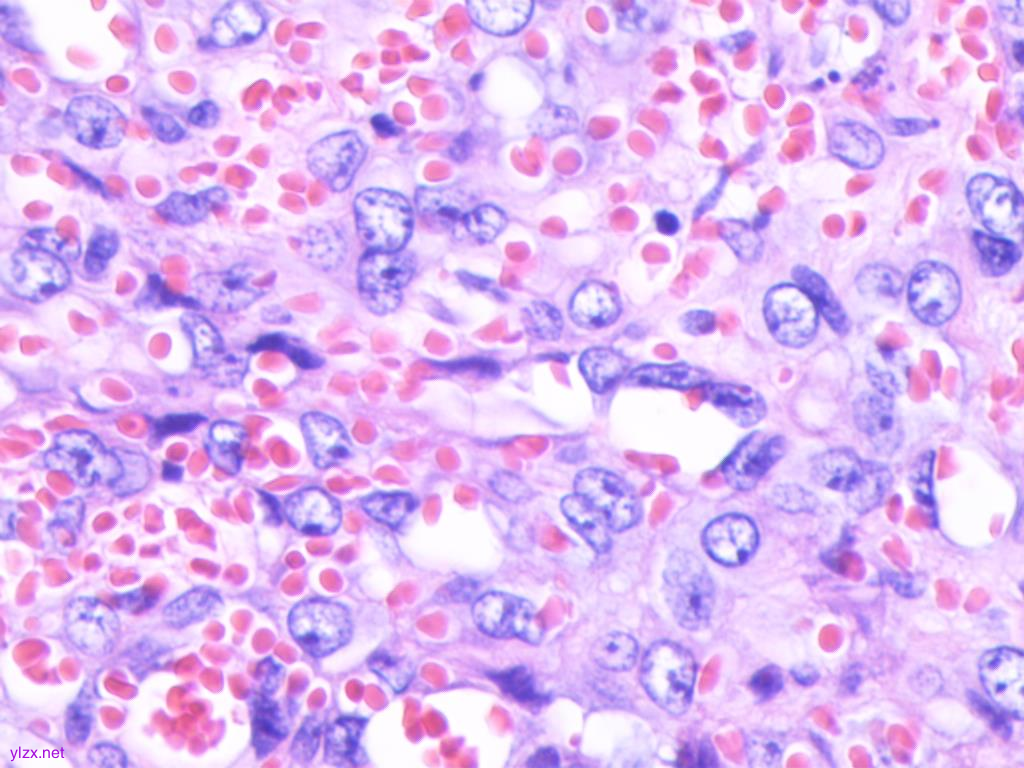
图片

【衡道丨病例】病理诊断——复合性血管内皮瘤
时间:2025-04-11 12:09:28 热度:37.1℃ 作者:网络
临床资料
患者,男性,51岁,无意间发现左面部肿物,约有“核桃”大小,有轻微自发痛,无明显触痛,无麻木不适,遂就诊我院口腔科。
面部CT平扫检查显示:
左颌下团块状软组织密度影,测量大小约3.8cm×3.0cm×2.8cm,增强扫描见团块不均匀强化,内可见斑片状强化影及血管影,病灶局部与左侧颌下腺及咬肌分界不清,周围脂肪密度稍增高,并在脂肪内发现增大淋巴结影。
完善相关检查后在局部麻醉下行颌下腺肿物切除术。
大体检查
巨检可见不规则组织一块,大小5.2cm×4.3cm×3.0cm,肿块书页状切开见直径4.0cm的结节状肿物,质地软嫩、似有厚包膜,切面有出血和坏死、颜色呈灰红色。
镜下所示
肿瘤富含血管呈浸润性生长(图1A);肿瘤细胞组织学上由比例不等的良性血管瘤、中间型血管瘤和恶性血管瘤成分混合组成:
(1)良性血管瘤区域示海绵状血管瘤(40%)+梭形细胞血管瘤(15%)+毛细血管瘤(5%),分化好的海绵状血管瘤镜下可见管腔内充满大量血液,由扩张薄壁的血管构成,管腔大小不一;分化好的梭形细胞血管瘤镜下可见管腔扩张主要由显著的梭形细胞组成,呈束状、片状、分散排列,细胞核相对一致且无异型性;分化好的毛细血管瘤由增生扩张的毛细血管构成,呈分叶状、结节状、簇状分布,血管腔无或有、有管腔的表现管腔细小、衬覆扁平单层上皮,可见核分裂象,但细胞无异型性且无病理性核分裂。
(2)中间型血管瘤区域由网状血管内皮瘤(15%)+血管内乳头状血管内皮瘤(10%)组成。网状血管内皮瘤特征是细长的分支状血管彼此吻合形成网状结构,类似正常睾丸网样血管,管腔衬覆靴钉样的内皮细胞,呈单层柱状排列,细胞核圆、染色深,特别是位于细胞基底部的内皮细胞,鞋钉样形态更显著,有时会呈火柴头样向腔面突出;血管内乳头状血管内皮瘤区域可见内皮细胞呈乳头状或肾小球样增生,乳头中央有玻璃样间质轴心,管腔表面衬覆鞋钉样的内皮细胞,胞质少呈淡嗜伊红色,胞核突出也呈鞋钉样或火柴头样向管腔突出,它与网状血管内皮瘤在谱系上有较多重合,关键鉴别点是乳头状皱褶的形成。
(3)恶性血管瘤区域显示有上皮样血管内皮瘤(10%;图1B)+高分化血管肉瘤(5%;图1C)两种成分,上皮样血管内皮瘤由分支状肿瘤性血管构成,可见梭形的嗜酸性内皮细胞呈索状排列,有些区域散在的上皮样细胞巢状分布排列呈现原始血管腔样,且腔内含有红细胞、坏死物质,细胞周围可见独特的黏液玻璃样间质;细胞核有中度异型性,分裂活性>1/10高倍镜视野。高分化血管肉瘤区域显示肿瘤细胞弥散片状分布在血管周围间质内,多形性和异型性不显著,局灶有坏死,可见核分裂象和巨核细胞。
颌下腺复合性血管内皮瘤患者的病理组织结果(HE):

图1A:肿瘤位于颌下腺内,有出血和坏死,富含血管呈浸润性生长 ×100
图1B:上皮样血管内皮瘤显示细胞椭圆形、胞浆丰富,核仁明显 × 200

图1C:高分化血管肉瘤显示肿瘤细胞有轻度异型性,有病理性核分裂 × 200
免疫组织化学表型:
ERG(图2A)、FLI-1、CD31、CD34、F8均在海绵状血管瘤、梭形细胞血管瘤、毛细血管瘤、网状血管内皮瘤、血管内乳头状血管内皮瘤、上皮样血管内皮瘤及高分化血管肉瘤的瘤细胞中阳性表达;且不同性质的血管肿瘤成分的瘤细胞SMA、EMA、CAMTA1、CK8/18、D2-40 (图2B) 均不表达;Ki-67 ( +约1% ~15%;图2C)。最终常规病理诊断: CHE(低度恶性),结合临床密切随诊。术后电话随访,患者暂未出现复发和转移。
颌下腺复合性血管内皮瘤1例患者的免疫组织化学结果(× 100):

图2A:血管内乳头状血管内皮瘤ERG阳性;

图2B:海绵状血管瘤区域D2-40阴性;

图2C:高分化血管肉瘤区域Ki-67 阳性
最终诊断
最终常规病理诊断:
CHE(低度恶性),结合临床密切随诊
讨论
复合性血管内皮瘤(CHE)是一种具有局部侵袭性、极少发生转移的血管源性肿瘤,该病由Nayler于2000年首先报道,主要是由比例不等的良性血管瘤、中间性血管瘤和恶性血管瘤成分混合构成(诊断标准必须具有两种及以上不同血管肿瘤成分)[1]。因CHE罕见,至今大宗病例报道较少。
临床特征:
CHE发病率极低,目前CHE的自然属性和生物学行为尚不完全清楚。已有报道发现CHE在婴幼儿、老年人均可发生,但多见于成人,女性多发,男女比例1:1.7,中位年龄为42.5岁[2-3],CHE多发在肢体远端的浅表软组织,尤其是在手足部位,少数病例可发生头颈、背部、肺、纵隔和腹股沟等部位,而发生在腮腺、颌下腺者更罕见。临床特征多是与周围组织分界不清的团块状肿物,在皮肤或黏膜内缓慢、浸润性生长,颜色与出血量有关、多呈红棕色或紫红色。术前肿瘤病程不定(3个月~10年)。
镜下特征:
CHE均由不同比例的良性、中间性和恶性血管成分混合构成,是一种低度恶性的血管源性肿瘤。良性成分可以是海绵状血管瘤、梭形细胞血管瘤、动静脉畸形、局限性淋巴管瘤;中间型成分多见网状血管内皮瘤、卡波西型血管内皮瘤和血管内乳头状血管内皮瘤;恶性成分则多以上皮样血管内皮瘤和血管肉瘤为主;Leen等[3]研究认为CHE是一种形态和组成成分较复杂的具有异质性的血管源性肿瘤,浸润性生长,具有膨胀性边缘与周围正常组织分界尚清楚,诊断标准至少需包含上述不同类型血管瘤的两种组合。文献报道的CHE多见的组合成分有梭形细胞血管瘤、网状血管内皮瘤、乳头状淋巴管内血管内皮瘤、上皮样血管内皮瘤、甚至血管肉瘤等,而海绵状血管瘤、淋巴管瘤、毛细血管瘤等成分则少见。本文报道的该例患者,主要成分是海绵状血管瘤(40%)+梭形细胞血管瘤(15%)+毛细血管瘤(5%)。
免疫组化特征:
免疫组织化学表型显示肿瘤细胞弥漫性表达ERG、FLI-1、CD31、CD34、F8,且不同血管肿瘤成分瘤细胞的SMA、EMA、CAMTA1、CK8/18均不表达。有报道[4-5]发现CHE有些病例中相关血管内皮细胞的标志物,如CD34会呈阴性或弱阳性表达,而部分肿瘤细胞核内有Prox-1的强表达,而Prox-1是与胚胎淋巴管芽生长、延伸、淋巴管内皮细胞表型改变密切相关的因子,它在内皮细胞中仅特异性地表达在胚胎淋巴管及肿瘤内淋巴管,当这类病例出现时,不要被内皮细胞失表达或表达弱血管源性标记而否定血管源性肿瘤的诊断,要基于CHE镜下内皮细胞形态特点,而这种血管标志物失/弱表达可以理解为肿瘤细胞向淋巴管分化导致。
分子遗传学特征:
有一些病例报告显示CHE可以表达神经内分泌的标志物[6],且具有神经内分泌分化的这类独特亚群的肿块发生位置通常较深,临床生物活性比经典型CHE病例具有更强的侵袭力,对其行分子基因检测发现存在EPC1::PHC2基因融合或PT-BP1::MAML2基因融合[7-8],但这两个基因异常能否是CHE的特异标志物还有待更多CHE病例大数据的分析,本例原发在颌下腺的CHE因镜下诊断未发现神经内分泌的区域,故未加做其相关基因检测。
治疗和预后
目前CHE的治疗主要是局部广泛扩大切除,对高度可疑有区域淋巴结转移的患者,可行局域淋巴结清扫,术后结合病理综合判断是否采取局部放疗,而对已经发生远处转移的患者,需行化疗。本患者术前影像查见有淋巴结肿大区域,故建议密切随访和局部放疗。有研究报道[9-10]的8个病例中看到大多血管肉瘤成分,6例随访6.5年有3例局部复发,仅1例发生在舌的病例转移至下颌骨淋巴结,8例均无死亡。Reis-Filhol等[11]报道发生在左前臂末肢端的CHE,未进行放化疗,前臂切除后患者生存7年。故大部分学者认为CHE的生物学侵袭性、恶性度要比普通血管肉瘤低,但考虑到肿瘤的复发会与肿瘤的不完全切除或肿瘤多中心的异质性本质相关,故对CHE患者的分期及外科治疗中要综合考虑,选择手术方式时要避免过度切除。本例患者术后电话随访(每隔3月),患者暂未出现复发和转移。
鉴别诊断
对CHE取材需充分,避免因取材不足而致镜下呈现的病变单一,导致误诊。CHE病理学特征的多样性和组成成分的复杂性更需要病理诊断时仔细、全面观察所有切片,对比分析肿瘤中良性、中间性和恶性血管区域组织结构、细胞形态特点,再与多种血管源性肿瘤进行鉴别诊断,避免因只观察到肿瘤的局部而忽视病变的整体。
(1)良性的网状血管内皮瘤和乳头状淋巴管内血管内皮瘤。这两种肿瘤在组织形态上有交叉、重叠性,其共性均可在扩张的血管腔内形成乳头簇,表面衬附靴钉样的内皮细胞,无或极少的核分裂象。网状血管内皮瘤中青年人好发,组织特征表现类似于正常睾丸网样的细长分支血管状,而Dabska瘤则在婴幼儿及儿童好发,组织特征表现为在淋巴管瘤样背景下可见大量的扩张的薄壁脉管,脉管周围常见玻璃样物质环绕和数量不等的淋巴细胞套状浸润。而CHE则可见这两种中间性血管肿瘤的成分单一或同时存在,且同时具有其他良性及恶性血管性肿瘤的区域。
(2)恶性特征的上皮样血管内皮瘤和高分化血管肉瘤。上皮样血管内皮瘤好发在软组织及肺、骨、脑等部位,中年女性多发,组织特征是瘤细胞呈散在、条索、小巢团状、片状排列分布,形态呈短梭、卵圆和圆形,胞质丰富,嗜伊红色,可见明显空泡状印戒样细胞,胞核部分空泡状,核仁不显著,多单个或三两成簇聚集,形成腺腔样,内含红细胞,即特征的原始血管腔。高分化血管肉瘤好发老年人的皮肤和软组织,组织特征是肿瘤成分较单一,不规则扩张性血管腔隙可沟通或吻合,在真皮内或皮下呈浸润性或破坏性生长,管腔衬附肿瘤细胞单层排列,核大深染;核有异型但不显著,而CHE肿瘤成分复杂、病程较长,且进展缓慢,生物学行为并未表现出有明显的侵袭性,故定义为交界性肿瘤。而血管肉瘤则表现侵袭度强,进展快,易发生远处转移,多为高度恶性肿瘤。
参考文献:
[1] Nayler SJ,Rubin BP,Calonje E,et al.Composite hemangioen-dothelioma: a complex,low-grade vascular lesion mimicking angio-sarcoma[J].Am J Surg Pathol,2000,24( 3) :352- 361.DOI: 10.1097/00000478-200003000-00003.
[2] 傅兴宁, 刘丽冰, 刘晓玲,等. 腮腺复合性血管内皮瘤一例[J]. 中华耳鼻咽喉头颈外科杂志, 2017, 52(12):2.
DOI:10.3760/cma.j.issn.1673-0860.2017.12.017
[3]Leen SL, Clarke PM, Chapman J, Fisher C, Thway K. Composite
Hemangioendothelioma of the Submandibular Region. Head Neck Pathol.2015 Dec;9(4):51-24.doi:10.1007/s12105-015-0612-6.Epub 2015 Feb 10
[4]Zhang J,Wu B,Zhou G Q,et al.Composite hemangioendothelio-ma arising from the kidney: case report with review of the literature[J].Int J Clin Exp Pathol,2013,6( 9) : 1935-1941.PMID: 24040461 PMCID: PMC3759503[5]Perry K D,Al-Lbraheemi A,Rubin B P,et al. omposite heman-gioendothelioma with neuroendocrine marker expression: an aggres-sive variant[J].Mod Pathol,2017,30( 11) : 1589 - 1602.Doi: 10.1038/modpathol.2017.83. Epub 2017 Jul 21
[6] 徐佳丽, 范钦和, 贡其星. 复合性血管内皮瘤伴神经内分泌标志物表达一例[J]. 中华病理学杂志, 2020, 49(6):3.
DOI:10.3760/cma.j.cn112151-20190905-00484
[7] 陈东, 方微, 肖磊,等. 肺复合性血管内皮瘤1例报道及文献复习[J]. 现代生物医学进展, 2008, 008(011):2047-2050.
[8] 曹丽娟, 王辉, 谢军. 脾脏复合性血管内皮瘤临床病理观察[J]. 诊断病理学杂志, 2019(2):4.
DOI:10.3969/j.issn.1007-8096.2019.02.011
[9]Mahmoudizad R,Samrao A,Bentow J J,et al.Composite heman-gioendothelioma: an unusual presentation of a rare vascular tumor[J].Am J Clin Pathol,2014,141 ( 5) : 732 -736.
Doi:10.1309/AJCPXEK50YPRNDHX.PMID:24713748
[10]Fukunaga M, Suzuki K, Saegusa N,等. 复合性血管内皮瘤5例报道[J]. 临床与实验病理学杂志, 2008, 24(3):1
Doi:10.1097/PAS.0b013e318038f6b5. PMID:17895759.
[11] Reis-Filho JS, Paiva ME, Lopes JM. Congenital composite
hemangioendothelioma: case report and reappraisal of the hemangioendothelioma spectrum. J Cutan Pathol.2002 Apr;29(4):226-31. doi: 10.1034/j.1600-0560.2002.290405.x

